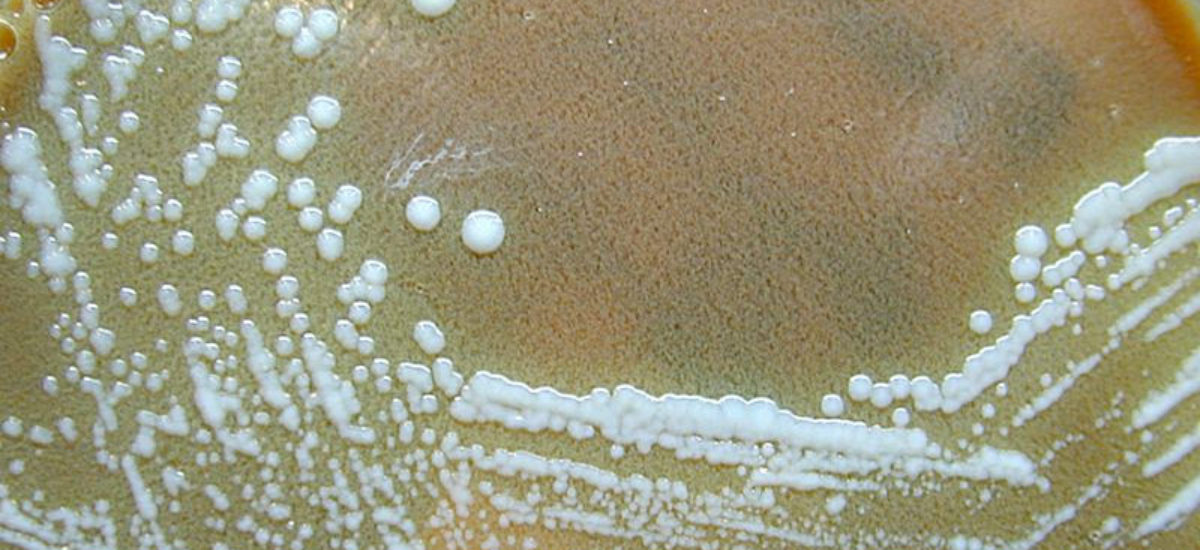

La acuicultura debe hacer frente, una vez superadas las primeras expectativas de producción, a nuevos retos relacionados con la sanidad y la seguridad de los productos. Uno de ellos son las enfermedades de los peces, que constituyen un importante factor de riesgo que limita la viabilidad de este tipo de producción, si se tiene en cuenta además que la mayoría de los patógenos bacterianos están adaptados ya tanto a aguas dulces como marinas. Desde hace años se trabaja para el control de este tipo de enfermedades, y un estudio acaba de dar con una nueva bacteria patógena que afecta al cultivo de bacalao en Noruega, la Francisella philomiragia noatunensis.
Imagen: Wikimedia
La producción mundial de la acuicultura en 2004 fue de 45,5 millones de toneladas y, durante el mismo año, el 43% de la cantidad total de pescado destinado al consumo humano procedió de este sector. Esto es lo que refleja el informe «El estado mundial de la pesca y la acuicultura» (SOFIA), de la Organización de las Naciones Unidas para la Agricultura y la Alimentación (FAO). En España, la producción representa el 3% de la mundial y el 25% de la europea. Las cifras son un claro indicador del continuo crecimiento de la acuicultura en todo el mundo, lo que lleva implícito que aparezcan nuevos retos a los que hacer frente. En el ámbito comunitario, donde se crían sobre todo peces de agua dulce y de mar y moluscos, una de las prioridades es garantizar la seguridad de los productos a través del fomento de la investigación de nuevas patologías.
Amenaza para el bacalao
La nueva bacteria detectada en bacalao de piscifactoría está presente de forma natural en las aguas costerasUno de estos estudios, realizado por expertos noruegos, acaba de dar con una nueva bacteria, que denominan «Francisella philomiragia noatunensis», de la familia «Francisella spp», que afectaría al cultivo de bacalao y que, según el Instituto Veterinario de Noruega, habría afectado al 40% de los ejemplares adultos de una piscicultura, causándoles la muerte en cinco meses. Si bien los trabajos realizados hasta el momento han determinado que la bacteria no crece a 37º C y que es difícil que pueda transferirse a animales de sangre caliente, los expertos desconocen aún cuál es su verdadera magnitud y si puede afectar también al bacalao salvaje.
Hasta ahora esta bacteria se había identificado en tilapia de Taiwán y en peces marinos de Japón, aseguran los responsables del estudio noruego, que apuestan por continuar la investigación para desentrañar las dudas que aún se ciñen sobre sus posibles efectos, como hasta qué punto puede afectar a los salmones. Lo que sí se sabe de esta bacteria es que vive en las células de pescados como el bacalao y el salmón y que está presente de forma natural en las aguas costeras, lo que indica que puede extenderse a otras especies marinas.
La contaminación por bacteria «Francisella philomiragia» ya ha sido considerada una enfermedad emergente de etiología bacteriana con efectos en los cultivos marinos, concretamente en especies como el bacalao, el mero, la lubina y la tilapia. Algunas de las investigaciones sugieren que el origen de enfermedades como ésta podría estar en las poblaciones salvajes de peces o mamíferos marinos, que actuarían como un importante reservorio de ciertos patógenos. Aunque los expertos no descartan que pueda encontrarse también en el medio acuático, puesto que se han aislado diferentes tipos de «Francisella» no sólo en los animales sino en el agua y el suelo.
El carácter emergente de la bacteria «Francisella philomiragia» vendría dado por su reciente detección, en el año 2000, cuando se describió el nuevo patógeno intracelular responsable de muertes de poblaciones de bacalao en Noruega o de mero en Taiwán.
El salmón
Junto al bacalao, el salmón es otra de las especies a la que la acuicultura dedica una parte importante de su atención. Y también lo hace la parte de investigación, que se está centrando en determinar cómo actúa y en qué grado afecta la bacteria «Piscirickettsia salmonis», descubierta en 1989 en Chile, donde ha causado importantes pérdidas en el sector acuícola, aunque también ha afectado a países como Canadá, EE.UU., Noruega, Escocia e Irlanda. Esta bacteria, cuando afecta a los salmones, provoca la enfermedad denominada piscirickettsiosis, que produce una importante mortalidad del pescado, especialmente durante la época de primavera y otoño, que es cuando la bacteria tiene mayor facilidad de replicarse (en unos 15 a 18° C).A finales de 2006, y según el informe “El estado mundial de la acuicultura”, de la FAO, casi la mitad del pescado que se consumía en todo el mundo procedía de la acuicultura y no del mar. Además de hacer frente a cuestiones relacionadas con el diferencias nutricionales o físicas, entre otras muchas, entre el pescado que se cría en cautividad o el que crece a mar abierto. La creencia es que el primero es de menor calidad, aunque la mayor parte de las investigaciones en este campo admiten que es muy difícil distinguir la diferencia entre uno y otro, y en cuanto a la calidad, no difiere mucho uno de otro.
En esta misma línea se pronunciaba la Autoridad Europea de Seguridad Alimentaria (EFSA) que en un informe admite que “no hay diferencias apreciables en términos de seguridad y valor alimenticio”. Pero el consumidor debe conocer la procedencia del pescado que encuentra en el mercado, y para ello cuenta con el etiquetado, que le ofrece esta información desde 2002, cuando algunas normativas europeas empezaron a obligar a mencionar el método de producción (pesca extractiva, pescado en aguas dulces, de acuicultura o marisqueo), el nombre de la zona donde se ha capturado o criado, el modo de presentación (eviscerado, cocido, fileteado, o descongelado, entre otros) y, en el caso de que esté envasado, el peso neto.